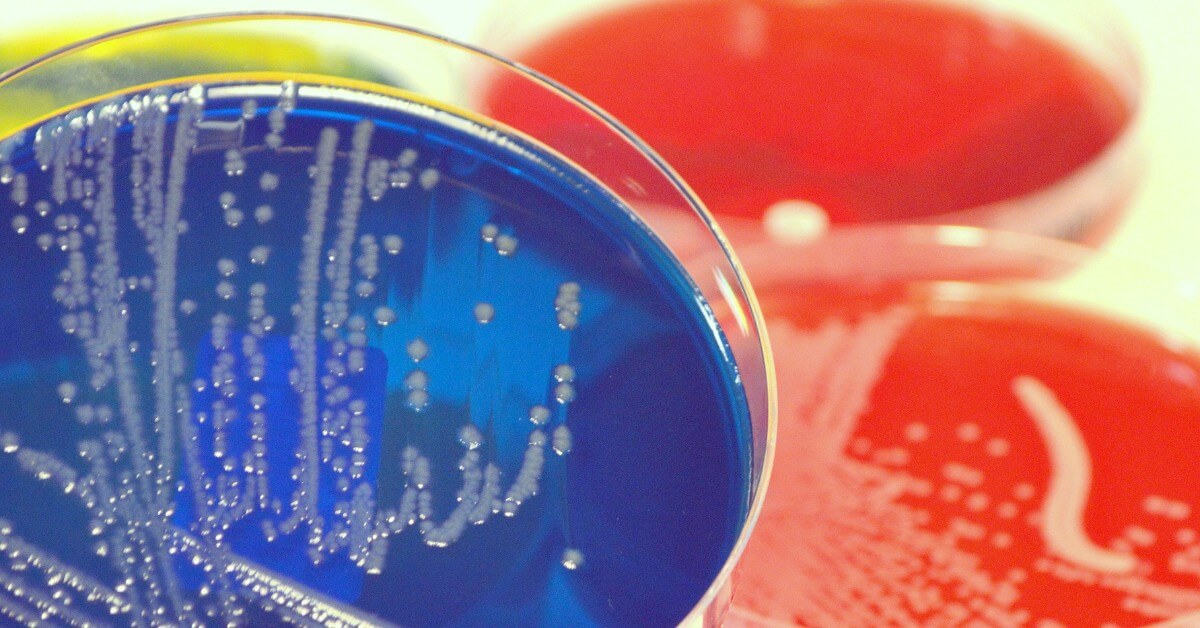
Przyczyny zaburzeń mikrobiomu

Pierwsze 1000 dni życia dziecka to kształtowanie się jego mikrobioty. Prawidłowa flora bakteryjna ma ogromny wpływ na dalszy rozwój i różne aspekty zdrowotne. Badania wykazały, że dzieci urodzone w czasie pandemii, a przede wszystkim podczas lockdownów, mają zmieniony mikrobiom. Jest on uboższy niż dzieci urodzonych w innych okresach.
Wiadomo, że flora jelitowa ma wpływ na zdrowie dziecka już od momentu jego przyjścia na świat. Najważniejszą jej funkcją jest aktywowanie i sprawne działanie układu immunologicznego (w przewodzie pokarmowym znajduje się 70% wszystkich limfocytów z organizmu), ale tych połączeń ze zdrowiem jest wiele, w ostatnim czasie podkreśla się także wpływ dobrych bakterii na metabolizm i wydatkowanie energetyczne organizmu. Wynika z niego, że zaburzenia w mikrobiomie mogą oddziaływać na kontrolę prawidłowej wagi, a jak wiadomo, otyłość staje się ogromnym globalnym problemem także u najmłodszych. Niektóre z bakterii pomagają trawić laktozę, co ma ogromne znaczenie dla niemowląt. Bakterie jelitowe dodatkowo mają wpływ na pracę mózgu, ich niekorzystny układ może przekładać się na spadek samopoczucia, a nawet zaburzenia typu depresja. Coraz lepiej znamy zależności między mikrobiotą a większością tak zwanych chorób cywilizacyjnych, a nawet z autyzmem (średnia autystyków z zaburzeniami pracy przewodu pokarmowego jest o wiele wyższa niż osób zdrowych). Lekarze podkreślają, że kontrolowanie mikrobiomu człowieka to przyszłość leczenia, utrzymanie go na prawidłowym poziomie pomoże uniknąć wielu chorób. Tym bardziej, że skład flory bakteryjnej u najmłodszych determinuje w dużym stopniu to, na jakie choroby zapadną, lub jakich unikną, w wieku dużo późniejszym. Mowa przykładowo o alergiach, na które bardziej narażone są dzieci z mniejszą ilością bakterii Bifidobacterium, Lactobacillus i Bacteroides.
Dziedziczone i nabyte
Do niedawna sądzono, że skład flory bakteryjnej zaczyna się ustalać od momentu narodzin, obecnie wiadomo już, że wpływ ma także to, co jadła matka, gdy była w ciąży. Część szczepów bakterii już wtedy zasiedla organizm małego człowieka. Mikroorganizmy zasiedlają jego układ pokarmowy przenikając z dróg rodnych i przewodu pokarmowego matki i uważa się to za najbardziej naturalny ze sposobów kształtowania się mikrobiomu dziecka. Wiele zależy od tego, co je matka, a potem od sposobu porodu (w przypadku carskiego cięcia różnorodność mikrobiomu jest niższa) i od sposobu karmienia dziecka. W mleku matki są substancje będące probiotykami, a także prebiotykami, które są pożywką również dla bakterii w jelitach dziecka i stymulują ich prawidłowy rozrost. W mleku są też oligosacharydy, które poza tym, że wspierają kolonizację ważnych dla prawidłowego rozwoju bakterii Bifidobacterium, zapobiegają też mnożeniu się drobnoustrojów patogennych.
Dzieci lockdown’u
Wszyscy wiemy, że dziecko poznaje świat także przez dotyk. Wsadza sobie różne rzeczy do ust, smakuje je, tym samym, chcąc nie chcąc, „aplikując” sobie kolejne porcje bakterii, wśród których są też te korzystnie wpływające na pracę organizmu. Podczas lockdown’u warunki życia były jednak bardzo specyficzne – dzieci nie wychodziły na zewnątrz, nie spotykały się z rówieśnikami, a czasem i nikim innym poza najbliższą rodziną (niektóre dzieci przez kilka miesięcy były zupełnie odcięte od kontaktów z obcymi), nie odwiedzały placów zabaw. Innymi słowy, nie miały styczności także z obcą florą bakteryjną. Jakby było tego mało, ich dieta była nieco inna (więcej produktów wysoko przetworzonych), o wiele bardziej dbano o higienę, sterylność. Opublikowane w „Scientific Reports” wyniki badań pokazują jasno, że mikrobiom dzieci urodzonych w czasie lockdownu jest uboższy niż ich rówieśników, którzy urodzili się wcześniej lub później. Niektórych ważnych szczepów bakterii w ich jelitach praktycznie nie znaleziono lub były one nieliczne. Co to oznacza? Przede wszystkim to, że w najbliższym czasie możemy się spodziewać wysypu alergii, atopii, zaburzeń psychicznych, chorób cywilizacyjnych u coraz młodszych osób. Pandemia zmieniła prawdopodobnie mikrobiom większości ludzi, ale u najmłodszych, których układ jelitowy jest bardziej plastyczny, te zmiany były wyraźniejsze niż u dorosłych. To także nauczka na przyszłość, by w razie ewentualnego kolejnego lockdownu zadbać o florę bakteryjną własną i dzieci, wkomponować w dietę substancje probiotyczne i prebiotyczne. Ten niepozorny detal może potem przełożyć się na długofalowe problemy ze zdrowiem.
https://instytut-mikroekologii.pl/wp-content/uploads/2017/12/Ksztaltowanie-sie-mikrobioty.pdf https://www.news-medical.net/news/20230831/Pandemic-may-have-altered-gut-microbiome-of-infants-study-finds.aspx https://www.ncbi.nlm.nih.gov/pmc/articles/PMC10432475/
Leave A Comment